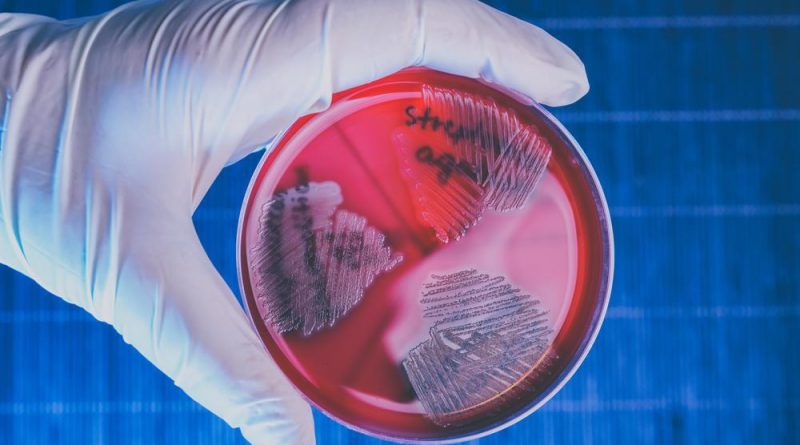

Μίχος: «Κορυφή του παγόβουνου οι μέχρι τώρα θάνατοι παιδιών από στρεπτόκοκκο τύπου Α»
«Οι θάνατοι που βλέπουμε τώρα είναι η κορυφή του παγόβουνου, καθώς από κάτω υπάρχουν χιλιάδες άλλες, απλές στρεπτοκοκκικές λοιμώξεις. Στα παιδιά έχουμε έξαρση από τον Οκτώβριο σε αυτές τις λοιμώξεις, οι οποίες μάλιστα υποτροπιάζουν», δηλώνει στο Πρακτορείο FM ο καθηγητής Παιδιατρικής- Λοιμωξιολογίας της Ιατρικής Σχολής Αθηνών και διευθυντής στην Α΄ Παιδιατρική Κλινική του «Αγία Σοφία», Αθανάσιος Μίχος.
Τα έξι περιστατικά που δεν είχαν καλή έκβαση δεν σημειώθηκαν τις τελευταίες εβδομάδες, αλλά είναι από τον Σεπτέμβριο μέχρι τώρα, επισημαίνει ο καθηγητής, για να συμπληρώσει στη συνέχεια ότι «κάθε χρόνο έχουμε θανάτους από στρεπτόκοκκο, απλά τώρα είναι μαζεμένα τα περιστατικά και για αυτό έχουν θορυβήσει τον κόσμο. Φυσικά είναι πολύ σωστή κίνηση του Υπουργείου να γίνεται συστηματική καταγραφή των διεισδυτικών λοιμώξεων, ανεξαρτήτως έκβασης, καθώς μέχρι τώρα δεν υπήρχε επιδημιολογική επιτήρηση».
Στο Ηνωμένο Βασίλειο, σημειώνει ο κ. Μίχος, έχουν σημειωθεί 480 θάνατοι σε όλες τις ηλικίες, με 43 παιδιά κάτω των 18 ετών. «Στη συνέχεια και άλλες ευρωπαϊκές χώρες ξεκίνησαν να βλέπουν τέτοιους αριθμούς περιστατικών, χωρίς όμως να φαίνεται ότι είναι διαφορετικά στελέχη, από αυτά που κυκλοφορούσαν τα προηγούμενα χρόνια. Ενδεχομένως ένας συνδυασμός ιώσεων και βακτηριακών λοιμώξεων, έχει ως αποτέλεσμα να έχουμε πολύ περισσότερα περιστατικά διεισδυτικής νόσου, δηλαδή της νόσου που μπορεί να κάνει βακτηριαιμία (σσ παρουσία βακτηρίων στο αίμα) ή άλλες επιπλοκές και να καταλήξει ο ασθενής σε θάνατο».
Τα lockdown συνέβαλαν στην έξαρση των αναπνευστικών λοιμώξεων
Τι ρόλο έχει παίξει άραγε η επιδημία του κορονοϊού στην αύξηση των κρουσμάτων με στρεπτόκοκκο τύπου Α΄, ερωτάται ο καθηγητής Παιδιατρικής Λοιμωξιολογίας: «Κάθε χρόνο εκτιθέμεθα σε πάρα πολλούς ιούς και βακτήρια και έτσι κάνουμε μία εποχική ανοσία, την οποία χάσαμε με τα χρόνια της πανδημίας, λόγω του εγκλεισμού, της αποστασιοποίησης και των μέτρων προστασίας. Τώρα όμως, που βγήκαν οι μάσκες και ξεκίνησε πάλι η κοινωνική ζωή, και κατά συνέπεια και η σχολική ζωή, τα παιδιά εκτέθηκαν απότομα σε πάρα πολλούς ιούς και βακτήρια συγχρόνως, με αποτέλεσμα να έχουμε αυτό το συνδυασμό έξαρσης όλων των αναπνευστικών λοιμώξεων. Φέτος είδαμε και επιθετικές λοιμώξεις από πνευμονιόκοκκο πολλές φορές, σοβαρές ωτίτιδες με επιπλοκές, παραρινοκολπίτιδες και άλλα περιστατικά που δεν φτάνουν στη δημοσιότητα. Άρα σίγουρα έπαιξε κάποιο ρόλο ο εγκλεισμός και η απομόνωση».
Σε εγρήγορση τα παιδιατρικά νοσοκομεία
Αυτή τη στιγμή υπάρχει μεγάλη εγρήγορση στο «Παίδων» και σε όλα τα παιδιατρικά νοσοκομεία, όπου καταγράφουμε τα περιστατικά και οι λοιμωξιολόγοι είμαστε σε συνεχή επαφή, λέει ο κ. Μίχος. «Φέτος ήταν μία χρονιά με πάρα πολλές λοιμώξεις. Ελπίζουμε ότι του χρόνου θα είναι καλύτερα. Επειδή τώρα το καλοκαίρι τα παιδιά φεύγουν από το σχολικό περιβάλλον που ευνοεί τη μετάδοση, και αυξάνονται και οι θερμοκρασίες, ελπίζουμε ότι θα έχουμε ύφεση των περιστατικών». Όσον αφορά τα μέτρα πρόληψης ο κ. Μίχος αναφέρει ότι ο στρεπτόκοκκος είναι μία λοίμωξη του αναπνευστικού που μεταφέρεται με σταγονίδια, άρα λοιπόν εφόσον υπάρχει συγχρωτισμός θα μεταφέρεται και ο στρεπτόκοκκος και οι άλλες αναπνευστικές λοιμώξεις, και ιογενείς και βακτηριακές.
«Υπάρχουν τα μέτρα υγιεινής, αλλά δεν νομίζω ότι ιδιαίτερα μπορούν να επηρεάσουν τη μετάδοση». Μία σημαντική παράμετρο που θίγει ο καθηγητής είναι το θέμα της υπερκατανάλωσης αντιβιοτικών, γιατί όπως εξηγεί: «Στο φάρυγγα μας έχουμε φορεία (σσ, όταν στο φάρυγγα μας έχουμε κάποιο βακτήριο ή ιό χωρίς συμπτώματα), η οποία έρχεται και παρέρχεται από πάρα πολλούς ιούς και βακτήρια. Το να μπούμε σε κυνήγι μαγισσών και να ψάχνουμε να βρούμε σε τι είμαστε φορείς και να ζητάμε από τους γιατρούς αντιβιοτικά δεν έχει κανένα νόημα. Γιατί τώρα με αυτή τη δημοσιότητα που πήρε το θέμα, πάνε όλοι και κάνουν ένα strep test στο φαρμακείο και μετά ζητάνε από τους γιατρούς αντιβιοτικά. Και μπορεί να είναι φορείς κάποιου ιού, χωρίς να έχουν κανένα σύμπτωμα, οπότε δεν χρειάζεται να λάβουν αγωγή».
Λουράντος: Συνιστώ ψυχραιμία
Αντιβιώσεις γενικά υπάρχουν με το σταγονόμετρο στο εμπόριο, δηλώνει από την πλευρά του στην ίδια εκπομπή ο πρόεδρος του Φαρμακευτικού Συλλόγου Αττικής Κωσταντίνος Λουράντος, εξηγώντας ότι ο στρεπτόκοκκος είναι ένα μικρόβιο στην κατηγορία των βακτηριδίων και η πάθηση που δημιουργεί αντιμετωπίζεται με αντιβίωση. «Αυτή τη στιγμή σημειώνεται μία έντονη φόρτιση στον κόσμο που ψάχνει από φαρμακείο σε φαρμακείο για να βρει αντιβίωση, την οποία έχει γράψει ο γιατρός. Βεβαίως είναι σε έλλειψη τα δύο βασικά αντιβιοτικά για την περίπτωση του στρεπτόκοκκου, ωστόσο χρειάζεται ψυχραιμία. Βλέπω ότι ο κόσμος που δεν βρίσκει το φάρμακο του, παθαίνει πανικό. Θεωρεί ότι το φάρμακο που λείπει είναι αναντικατάστατο για αυτόν, πράγμα το οποίο δεν υφίσταται, εφόσον μπορεί να υπάρχει κάποιο γενόσημο, το οποίο μπορεί να αντιμετωπίσει την κατάσταση εξίσου αποτελεσματικά. Σταδιακά όμως άρχισαν να υπάρχουν και στα γενόσημα ελλείψεις. Από την άλλη υπάρχει και κόσμος που δεν θέλει με τίποτα να πάρει γενόσημο. Σε κάθε περίπτωση πρέπει όλοι να καταλάβουν πως αν έχουν μία φαρυγγίτιδα, ή πυρετό δεν σημαίνει ότι έχουν απαραίτητα στρεπτόκοκκο. Και το κυριότερο να μην πανικοβάλλονται».
Πρέπει να γίνει ένας εξορθολογισμός των τιμών σε όλα τα φάρμακα
Όσον αφορά το θέμα των ελλείψεων, ο πρόεδρος του φαρμακευτικού συλλόγου Αττικής λέει ότι το μέγεθος των τωρινών ελλείψεων είναι κάτι που αντιμετωπίζει πρώτη φορά στη διαδρομή του ως φαρμακοποιός. «Κάθε μέρα οι ελλείψεις μεγαλώνουν. Υπάρχει μία μη σωστή οικονομική αντιμετώπιση του προβλήματος, υπό την έννοια ότι όταν μία εταιρεία σου στέλνει ένα έγγραφο και σου λέει ότι εγώ με τις τιμές που μου δίνετε δεν μπορώ να συνεχίσω να εφοδιάζω την Ελλάδα, κάτι πρέπει να κάνεις. Όταν μάλιστα δίνεις εντολή στον ΙΦΕΤ να φέρει ένα φάρμακο και από 100 ευρώ που κάνει στην Ελλάδα, το φέρνει με 300 ευρώ, υπάρχει κάποιο πρόβλημα. Θα πρέπει να γίνει ένας εξορθολογισμός των τιμών σε όλα τα φάρμακα και να σταματήσουν να μιλάνε για πολιτικό κόστος. Η κυβέρνηση που θα προκύψει θα πρέπει να κάνει ένα σωστό ορθολογιστικό έλεγχο των τιμών και όσα φάρμακα πρέπει να πάρουν έστω και μία μικρή αύξηση για να παραμείνουν στην ελληνική αγορά, να την πάρουν. Όταν υπάρχει ένα φάρμακο σε έλλειψη, τότε ο γιατρός μπορεί να δώσει ένα άλλο, το οποίο μπορεί να είναι και πέντε φορές ακριβότερο. Και αυτό ίσως να βολεύει την εταιρεία. Έτσι, αρχίζει να αντικαθιστά το φάρμακο που είναι φθηνό με ακριβότερα. Και αυτό έχει μία επιβάρυνση στην κατανάλωση, στην τσέπη του καταναλωτή, και στα ασφαλιστικά ταμεία».